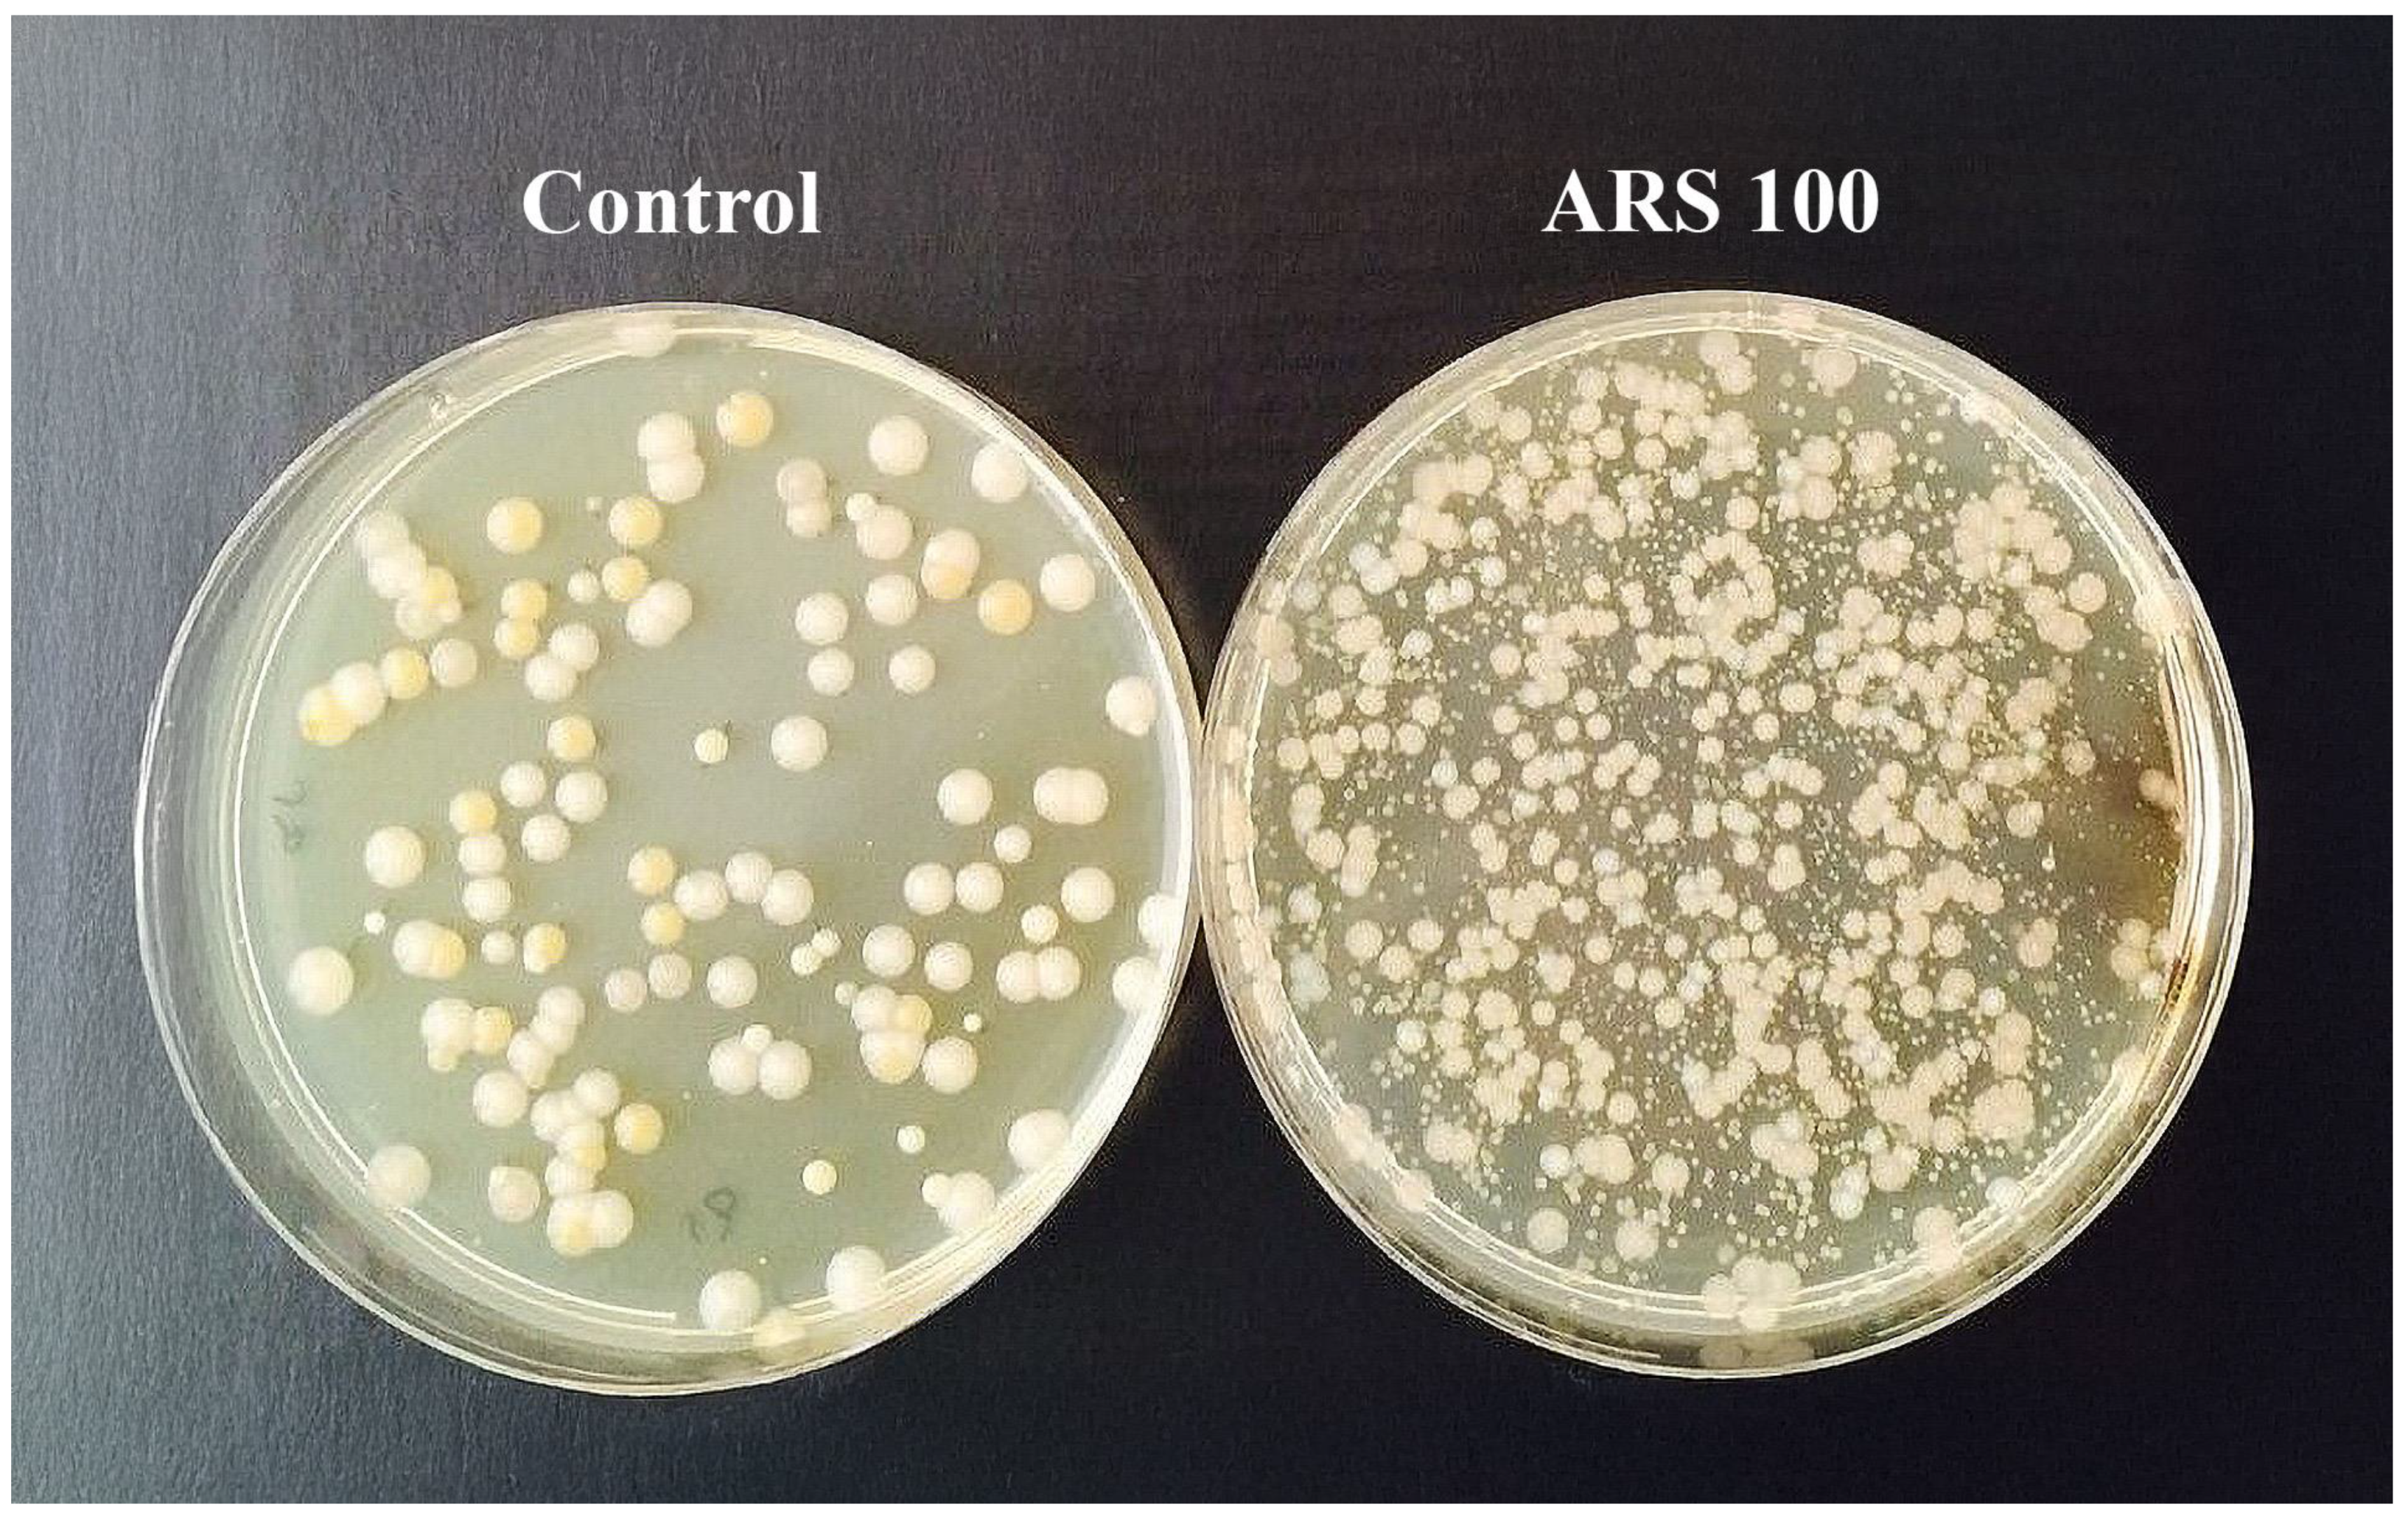
Fishes 10 00624 g001

Immediate and Delayed Impacts of Alizarin Red S Dye on Salmo trutta Fry: Physiological and Fitness Responses
Abstract
1. Introduction
2. Materials and Methods
3. Results
3.1. Short Experiment
3.2. Prolonged Experiment
4. Discussion
5. Conclusions
Author Contributions
Funding
Institutional Review Board Statement
Informed Consent Statement
Data Availability Statement
Acknowledgments
Conflicts of Interest
Abbreviations
| ARS | Alizarin Red S |
| CFU | Colony forming units |
| GVF | Gill ventilation frequency |
| KF | Fulton condition factor |
| RAS | Recirculating aquaculture system |
| TL | Total length |
| W | Total weight |
References
- HELCOM. Sea Trout Populations and Rivers in the Baltic Sea; Helsinki Commission: Helsinki, Finland, 2022. [Google Scholar]
- Jonsson, B.; Jonsson, N. Ecology of Atlantic Salmon and Brown Trout: Habitat as a Template for Life Histories; Springer: Dordrecht, The Netherlands, 2011. [Google Scholar]
- Klemetsen, A.; Amundsen, P.A.; Dempson, J.B.; Jonsson, B.; Jonsson, N.; O’Connell, M.F.; Mortensen, E. Atlantic salmon Salmo salar L.; brown trout Salmo trutta L. and Arctic charr Salvelinus alpinus (L.): A review of aspects of their life histories. Ecol. Freshw. Fish 2003, 12, 1–59. [Google Scholar] [CrossRef]
- Muñoz-Mas, R.; Vezza, P.; Martínez-Capel, F.; Alcaraz-Hernández, J.D. Spawning Habitat Degradation and Loss of Brown Trout (Salmo trutta) in the Upper Ebro River Basin under Climate Change Scenarios. Ecol. Model. 2018, 384, 138–151. [Google Scholar]
- Aprahamian, M.W.; Smith, K.M.; McGinnity, P.; McKelvey, S.; Taylor, J. Restocking of salmonids—Opportunities and limitations. Fish. Res. 2003, 62, 211–227. [Google Scholar] [CrossRef]
- HELCOM. Sea Trout Populations and Rivers in the Baltic Sea—HELCOM Assessment for 2011; Baltic Sea Environment Proceedings 132; HELCOM: Helsinki, Finland, 2011. [Google Scholar]
- Araki, H.; Schmid, C. Is hatchery stocking a help or harm? Evidence, limitations and future directions in ecological and genetic surveys. Aquaculture 2010, 308 (Suppl. S1), S2–S11. [Google Scholar] [CrossRef]
- Kesminas, V. Lietuvos Lašišinės Žuvys: Biologija, Ekologija ir Išteklių Apsauga; Gamtos Tyrimų Centras: Vilnius, Lithuania, 2023. [Google Scholar]
- Pinter, K.; Weiss, S.; Lautsch, E.; Unfer, G. Survival and growth of hatchery and wild brown trout (Salmo trutta) parr in three Austrian headwater streams. Ecol. Freshw. Fish 2017, 27, 146–157. [Google Scholar] [CrossRef]
- Volk, E.C.; Schroder, S.L.; Grimm, J.J. Otolith thermal marking. Fish. Res. 1999, 43, 205–219. [Google Scholar] [CrossRef]
- Gillanders, B.M. Using elemental chemistry of fish otoliths to determine connectivity between estuarine and coastal habitats. Estuar. Coast. Shelf Sci. 2005, 64, 47–57. [Google Scholar] [CrossRef]
- Liu, Q.; Zhang, X.M.; Zhang, P.D.; Nwafili, S.A. The use of alizarin red S and alizarin complexone for immersion marking Japanese flounder Paralichthys olivaceus (T.). Fish. Res. 2009, 98, 67–74. [Google Scholar] [CrossRef]
- Baer, J.; Rösch, R. Mass-marking of brown trout (Salmo trutta L.) larvae by alizarin: Method and evaluation of stocking. J. Appl. Ichthyol. 2008, 24, 44–49. [Google Scholar] [CrossRef]
- Lü, H.; Chen, H.; Fu, M.; Peng, X.; Xi, D.; Zhang, Z. Experimental evaluation of calcein and alizarin red S for immersion marking grass carp (Ctenopharyngodon idellus). Fish. Sci. 2015, 81, 653–662. [Google Scholar] [CrossRef]
- Campana, S.E. Otolith science entering the 21st century. Mar. Freshw. Res. 2005, 56, 485–495. [Google Scholar] [CrossRef]
- Warren-Myers, F.; Dempster, T.; Swearer, S.E. Otolith mass marking techniques for aquaculture and restocking: Benefits and limitations. Rev. Fish Biol. Fish. 2018, 28, 485–501. [Google Scholar] [CrossRef]
- Crook, D.; O’Mahony, D.J.; Gillanders, B.M.; Munro, A.R.; Sanger, A.C. Quantitative measurement of calcein fluorescence for non-lethal, field-based discrimination of hatchery and wild fish. In Advances in Fish Tagging and Marking Technology; McKenzie, J., Parsons, B., Seitz, A.C., Kopf, R.K., Mesa, M., Phelps, Q., Eds.; American Fisheries Society: Bethesda, MD, USA, 2012; pp. 389–396. [Google Scholar]
- Unfer, K.; Pinter, K. Marking otoliths of brown trout (Salmo trutta L.) embryos with alizarin red S. J. Appl. Ichthyol. 2013, 29, 470–473. [Google Scholar] [CrossRef]
- Kerr, L.A.; Campana, S.E. Chemical Composition of Fish Hard Parts as a Natural Marker of Fish Stocks. In Stock Identification Methods: Applications in Fishery Science, 2nd ed.; Cadrin, S.X., Kerr, L.A., Mariani, S., Eds.; Elsevier: San Diego, CA, USA, 2013; pp. 205–234. [Google Scholar] [CrossRef]
- Lejk, A.M.; Radtke, G. Effect of marking Salmo trutta lacustris L. larvae with alizarin red S on their subsequent growth, condition, and distribution as juveniles in a natural stream. Fish. Res. 2021, 234, 105786. [Google Scholar] [CrossRef]
- Simon, J.; Wickström, H. Long-term retention of alizarin red S marks and coded wire tags in European eels. Fish. Res. 2020, 224, 105453. [Google Scholar] [CrossRef]
- Turek, J.; Lepič, P.; Bořík, A.; Galicová, P.; Nováková, P.; Avramović, M.; Randák, T. Evaluation of large-scale marking with alizarin red S in different age rainbow trout fry for nonlethal field identification. Acta Ichthyol. Piscat. 2024, 54, 43–48. [Google Scholar] [CrossRef]
- Caudron, A.; Champigneulle, A. Multiple marking of otoliths of brown trout (Salmo trutta L.) with alizarin red S to compare efficiency of stocking of three early life stages. Fish. Manag. Ecol. 2009, 16, 219–224. [Google Scholar] [CrossRef]
- Meyer, S.; Sørensen, S.R.; Peck, M.A.; Støttrup, J.G. Sublethal effects of alizarin complexone marking on Baltic cod (Gadus morhua) eggs and larvae. Aquaculture 2012, 324–325, 158–164. [Google Scholar] [CrossRef]
- Egerton, S.; Culloty, S.; Whooley, J.; Stanton, C.; Ross, R.P. The Gut Microbiota of Marine Fish. Front. Microbiol. 2018, 9, 873. [Google Scholar] [CrossRef]
- Llewellyn, M.S.; Boutin, S.; Hoseinifar, S.H.; Derome, N. Teleost microbiomes: The state of the art in their characterization, manipulation and importance in aquaculture and fisheries. Front. Microbiol. 2014, 5, 207. [Google Scholar] [CrossRef]
- Talwar, C.; Nagar, S.; Lal, R.; Negi, R.K. Fish Gut Microbiome: Current Approaches and Future Perspectives. Indian J. Microbiol. 2018, 58, 397–414. [Google Scholar] [CrossRef] [PubMed]
- Ghanbari, M.; Kneifel, W.; Domig, K.J. A new view of the fish gut microbiome: Advances from next-generation sequencing. Aquaculture 2015, 448, 464–475. [Google Scholar] [CrossRef]
- Campana, S.E.; Thorrold, S.R. Otoliths, increments, and elements: Keys to a comprehensive understanding of fish populations? Can. J. Fish. Aquat. Sci. 2001, 58, 30–38. [Google Scholar] [CrossRef]
- ISO 7346-1:1996; Water Quality—Determination of the Acute Lethal Toxicity of Substances to a Freshwater Fish (Brachydanio rerio Hamilton-Buchanan)—Part 1: Static Method. International Organization for Standardization: Geneva, Switzerland, 1996.
- Caudron, A.; Champigneulle, A. Technique de fluoromarquage en masse à grande échelle des otolithes d’alevins vésiculés de truite commune (Salmo trutta L.) à l’aide de l’alizarine red S. Cybium 2006, 30, 65–72. [Google Scholar]
- Jurgelėnė, Ž.; Montvydienė, D.; Šemčuk, S.; Stankevičiūtė, M.; Sauliutė, G.; Pažusienė, J.; Morkvėnas, A.; Butrimienė, R.; Jokšas, K.; Pakštas, V.; et al. The impact of co-treatment with graphene oxide and metal mixture on Salmo trutta at early development stages: The sorption capacity and potential toxicity. Sci. Total Environ. 2022, 838, 156525. [Google Scholar] [CrossRef]
- Kakakhel, M.A.; Narwal, N.; Kataria, N.; Johari, S.A.; Zaheer Ud Din, S.; Jiang, Z.; Khoo, K.S.; Xiaotao, S. Deciphering the dysbiosis caused in the fish microbiota by emerging contaminants and its mitigation strategies—A review. Environ. Res. 2023, 237, 117002. [Google Scholar] [CrossRef]
- Evariste, L.; Barret, M.; Mottier, A.; Mouchet, F.; Gauthier, L.; Pinelli, E. Gut microbiota of aquatic organisms: A key endpoint for ecotoxicological studies. Environ. Pollut. 2019, 248, 989–999. [Google Scholar] [CrossRef]
- Butt, R.L.; Volkoff, H. Gut microbiota and energy homeostasis in fish. Front. Endocrinol. 2019, 10, 9. [Google Scholar] [CrossRef]
- Jin, Y.; Wu, S.; Zeng, Z.; Fu, Z. Effects of environmental pollutants on gut microbiota. Environ. Pollut. 2017, 222, 1–9. [Google Scholar] [CrossRef]
- Vargas-Albores, F.; Martínez-Córdova, L.R.; Hernández-Mendoza, A.; Cicala, F.; Lago-Lestón, A.; Martínez-Porchas, M. Therapeutic modulation of fish gut microbiota, a feasible strategy for aquaculture? Aquaculture 2021, 544, 737050. [Google Scholar] [CrossRef]
- Xavier, R.; Severino, R.; Silva, S.M. Signatures of dysbiosis in fish microbiomes in the context of aquaculture. Rev. Aquac. 2024, 16, 706–731. [Google Scholar] [CrossRef]
- Zhai, Q.; Yu, L.; Li, T.; Zhu, J.; Zhang, C.; Zhao, J.; Zhang, H.; Chen, W. Effect of dietary probiotic supplementation on intestinal microbiota and physiological conditions of Nile tilapia (Oreochromis niloticus) under waterborne cadmium exposure. Antonie Van Leeuwenhoek 2017, 110, 501–513. [Google Scholar] [CrossRef] [PubMed]
- See, M.S.; Ching, X.L.; Khoo, S.C.; Abidin, S.Z.; Sonne, C.; Ma, N.L. Aquatic microbiomes under stress: The role of gut microbiota in detoxification and adaptation to environmental exposures. J. Hazard. Mater. Adv. 2025, 17, 100612. [Google Scholar] [CrossRef]
- Shen, Y.; Fan, N.; Ma, S.X.; Cheng, X.; Yang, X.; Wang, G. Gut Microbiota Dysbiosis: Pathogenesis, Diseases, Prevention, and Therapy. MedComm 2025, 6, e70168. [Google Scholar] [CrossRef]
- Witeska, M.; Kondera, E.; Bojarski, B. Hematological and Hematopoietic Analysis in Fish Toxicology—A Review. Animals 2023, 13, 2625. [Google Scholar] [CrossRef]
- Meuthen, D.; Meuthen, I.; Bakker, T.C.M.; Thünken, T. Anticipatory plastic response of the cellular immune system in the face of future injury: Chronic high perceived predation risk induces lymphocytosis in a cichlid fish. Oecologia 2020, 194, 597–607. [Google Scholar] [CrossRef]
- Sharma, S.; Andotra, M.; Kaur, A. Cytogenotoxicity and Hematological Alterations Induced by the Environmentally Relevant Concentration of Low-Density Polyethylene Microplastics and Nickel Oxide Nanoparticles in Cirrhinus mrigala (Ham.). J. Appl. Toxicol. 2025, 44, 1416–1425. [Google Scholar] [CrossRef]
- Nabi, N.; Ahmed, I.; Wani, G.B. Hematological and serum biochemical reference intervals of rainbow trout, Oncorhynchus mykiss cultured in Himalayan aquaculture: Morphology, morphometrics and quantification of peripheral blood cells. Saudi J. Biol. Sci. 2022, 29, 2942–2957. [Google Scholar] [CrossRef]
- Agarwal, D.; Shanmugam, S.A.; Kathirvelpandian, A.; Eswaran, S.; Rather, M.A.; Rakkannan, G. Unraveling the Impact of Climate Change on Fish Physiology: A Focus on Temperature and Salinity Dynamics. J. Appl. Ichthyol. 2024, 2024, 5782274. [Google Scholar] [CrossRef]
- Czerniawski, R.; Pilecka-Rapacz, M.; Domagała, J. Growth and survival of brown trout fry (Salmo trutta m. fario L.) in the wild, reared in the hatchery on different feed. Electron. J. Pol. Agric. Univ. 2010, 13, 4. [Google Scholar]
- Koski, A.; Koljonen, S.; Syrjänen, J.T. Fast colonization of wild brown trout in nature-like compensation channel. River Res. Appl. 2024, 41, 581–592. [Google Scholar] [CrossRef]

| Group | N | TL (mean ± SD) | Q (mean ± SD) | KF (mean ± SD) |
|---|---|---|---|---|
| Initial | 300 | 49.7 ± 0.4 | 1.1 ± 0.2 | 0.89 ± 0.08 |
| Marked | 118 | 84.0 ± 1.0 | 6.0 ± 2.3 | 0.97 ± 0.05 |
| Non-marked | 124 | 88.8 ± 1.1 | 7.5 ± 2.7 | 1.02 ± 0.05 |
| Parameter | N | Initial (mean ± SD) | Marked (mean ± SD) |
|---|---|---|---|
| Erythrocytes (×106/µL) | 20 | 0.87 ± 0.29 | 0.84 ± 0.27 |
| Leukocytes (×103/µL) | 20 | 20.75 ± 10.36 | 25.95 ± 12.45 |
Disclaimer/Publisher’s Note: The statements, opinions and data contained in all publications are solely those of the individual author(s) and contributor(s) and not of MDPI and/or the editor(s). MDPI and/or the editor(s) disclaim responsibility for any injury to people or property resulting from any ideas, methods, instructions or products referred to in the content. |
© 2025 by the authors. Licensee MDPI, Basel, Switzerland. This article is an open access article distributed under the terms and conditions of the Creative Commons Attribution (CC BY) license (https://creativecommons.org/licenses/by/4.0/).
Share and Cite
Račkauskas, S.; Montvydienė, D.; Jurgelėnė, Ž.; Skrodenytė-Arbačiauskienė, V.; Virbickas, T.; Poviliūnas, J.; Rakauskas, V. Immediate and Delayed Impacts of Alizarin Red S Dye on Salmo trutta Fry: Physiological and Fitness Responses. Fishes 2025, 10, 624. https://doi.org/10.3390/fishes10120624
Račkauskas S, Montvydienė D, Jurgelėnė Ž, Skrodenytė-Arbačiauskienė V, Virbickas T, Poviliūnas J, Rakauskas V. Immediate and Delayed Impacts of Alizarin Red S Dye on Salmo trutta Fry: Physiological and Fitness Responses. Fishes. 2025; 10(12):624. https://doi.org/10.3390/fishes10120624
Chicago/Turabian StyleRačkauskas, Simonas, Danguolė Montvydienė, Živilė Jurgelėnė, Vesta Skrodenytė-Arbačiauskienė, Tomas Virbickas, Justas Poviliūnas, and Vytautas Rakauskas. 2025. "Immediate and Delayed Impacts of Alizarin Red S Dye on Salmo trutta Fry: Physiological and Fitness Responses" Fishes 10, no. 12: 624. https://doi.org/10.3390/fishes10120624
APA StyleRačkauskas, S., Montvydienė, D., Jurgelėnė, Ž., Skrodenytė-Arbačiauskienė, V., Virbickas, T., Poviliūnas, J., & Rakauskas, V. (2025). Immediate and Delayed Impacts of Alizarin Red S Dye on Salmo trutta Fry: Physiological and Fitness Responses. Fishes, 10(12), 624. https://doi.org/10.3390/fishes10120624






